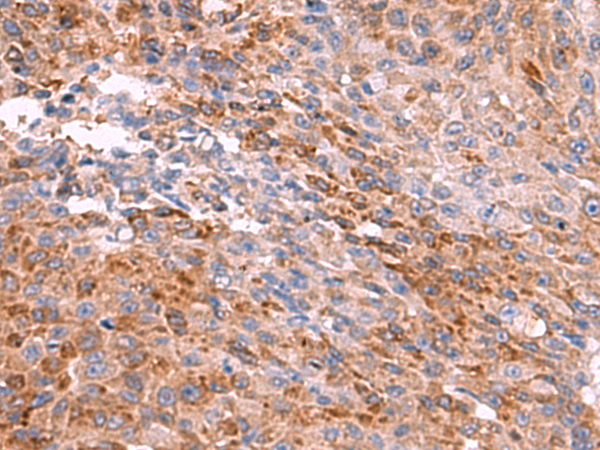

中文名稱: 兔抗PEMT多克隆抗體
英文名稱: Anti-PEMT rabbit polyclonal antibody
別 名: phosphatidylethanolamine N-methyltransferase; PLMT; PNMT; PEAMT; PEMPT; PEMT2
相關類別: 一抗
儲 存: 冷凍(-20℃)
宿 主: Rabbit
抗 原: PEMT
反應種屬: Human, Mouse
標 記 物: Unconjugate
克隆類型: rabbit polyclonal
技術規格
|
Background: |
Phosphatidylcholine (PC) is the most abundant mammalian phospholipid. This gene encodes an enzyme which converts phosphatidylethanolamine to phosphatidylcholine by sequential methylation in the liver. Another distinct synthetic pathway in nucleated cells converts intracellular choline to phosphatidylcholine by a three-step process. The protein isoforms encoded by this gene localize to the endoplasmic reticulum and mitochondria-associated membranes. Alternate splicing of this gene results in multiple transcript variants encoding different isoforms. |
|
Applications: |
ELISA, WB, IHC |
|
Name of antibody: |
PEMT |
|
Immunogen: |
Synthetic peptide of human PEMT |
|
Full name: |
phosphatidylethanolamine N-methyltransferase |
|
Synonyms: |
PLMT; PNMT; PEAMT; PEMPT; PEMT2 |
|
SwissProt: |
Q9UBM1 |
|
ELISA Recommended dilution: |
5000-10000 |
|
IHC positive control: |
Human colorectal cancer |
|
IHC Recommend dilution: |
50-300 |
|
WB Predicted band size: |
22 kDa |
|
WB Positive control: |
Mouse liver tissue, HepG2, 293T and 231 cell lysates |
|
WB Recommended dilution: |
1000-5000 |

購物車
購物車 幫助
幫助
 021-54845833/15800441009
021-54845833/15800441009
